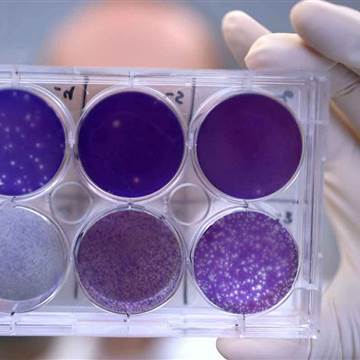

Researchers reported two steps toward fighting the Zika virus Monday — one from a team that has found a potential way to protect unborn babies from the virus, and a second from a team that announced the start of human trials of a new vaccine.
Neither offers immediate relief against the epidemic of Zika that has swept across the Americas and the Caribbean and parts of Asia, but they both provide hope of eventually being able to protect pregnant women and their babies from the infection.

The treatment is based on the body’s own defenses — an immune system particle called a monoclonal antibody that homes in specifically on the virus. In mice, it helped decrease the damage that the virus causes to developing fetuses and it also helped protect adult mice against infection in the first place.
“This is the first antiviral that has been shown to work in pregnancy to protect developing fetuses from Zika virus,” said Dr. Michael Diamond at Washington University School of Medicine in St. Louis, who helped lead the research.
Related: Company gets OK to Test Zika Vaccine
“This is proof of principle that Zika virus during pregnancy is treatable, and we already have a human antibody that treats it, at least in mice,” Diamond added.
Zika virus doesn’t cause serious disease in most people, but it causes profound birth defects in babies infected in the womb. The virus, transmitted by mosquitoes and through sex, can also cause rare neurological syndromes in a few adults.
“This is proof of principle that Zika virus during pregnancy is treatable, and we already have a human antibody that treats it, at least in mice.”
Mice don’t naturally catch Zika, so the study is not completely able to predict what would happen in people. But lab mice bred to be susceptible to Zika show some of the same effects that humans do, with the virus going into the brains of developing fetuses and causing extensive damage.
The team scanned blood samples from people who had been infected with Zika, looking for antibodies that appeared especially effective against Zika. They found one that looked especially effective and named it ZIKV-117.
“Even a single ZIKV-117 dose given five days after infection protected mice against lethal infection,” they wrote in a report published in the journal Nature.
When they gave the antibody to pregnant female mice either just before or just after infection, it reduced how quickly the virus invaded tissue.
“These naturally occurring antibodies isolated from humans represent the first medical intervention that prevents Zika infection and damage to fetuses,” said Dr. James Crowe of Vanderbilt University School of Medicine in Tennessee, who also worked on the study.
Related: Pregnant Women Warned to Steer Clear of Zika Zone in Miami
The antibodies did not appear to be dangerous to the developing mouse pups, said Indira Mysorekar at Washington University. “The anti-Zika antibodies are able to keep the fetus safe from harm by blocking the virus from crossing the placenta.”
It’s still a long way from testing in people. Pregnant women would be the No. 1 target for any Zika therapy, and doctors will need to be very sure that a treatment is both safe and effective before trying it in pregnant women.
But the researchers say their findings also increase hope that a vaccine might be effective.
A second team started human trials of a Zika vaccine Monday. It’s an unusual trial — they will first vaccinate two-thirds of the volunteers against other, related viruses to see if that makes a difference.
That’s because Zika belongs to an unusual family of viruses that includes dengue virus and the yellow fever virus. Doctors have long known that dengue virus has unusual effects on the human immune system.
Related: Full NBC News Coverage of Zika
People who are infected with dengue once don’t usually get very sick. But if they get infected with a second strain of dengue, their risk of dangerous dengue hemorrhagic fever goes up.
There are some indications that Zika may be affected by previous dengue infections.
So Dr. Kayvon Modjarrad, who helps lead the Zika program at the Walter Reed Army Institute of Research, says volunteers will have to be free of any previous infection with or vaccination against yellow fever, dengue or Japanese encephalitis.
Those getting Zika vaccines will be divided into three groups. One will just get a Zika vaccine.
“One of the groups is going to be given the Japanese encephalitis virus first and then wait a period of time and then get the Zika vaccine,” Modjarrad said. “Another group will get a yellow fever vaccine, wait a few months and then get a Zika vaccine.”
Related: Companies Say a Zika Vaccine Could be Profitable
Military personnel often get yellow fever and Japanese encephalitis vaccines, so the researchers want to make sure a previous vaccination doesn’t interfere with the new Zika vaccine.
Later, teams will test people who’ve had natural dengue, yellow fever or other viral infections to see if their immune response to those infections affects how the Zika vaccine works.
The vaccine has shown good effects in monkeys. It’s made using Zika viruses inactivated by chemicals, and is based on an existing vaccine that protects against Japanese encephalitis.
The volunteers will be tested to see if their bodies produce a healthy response that would be expected to protect them against infection.
Related: More Than a Million Moms at Zika Risk
…


![[Video] Master Key for Manufacturing Applied to Virus Test](https://loginby.com/itnews/wp-content/uploads/2020/07/video-master-key-for-manufacturing-applied-to-virus-test-238x178.jpg)



